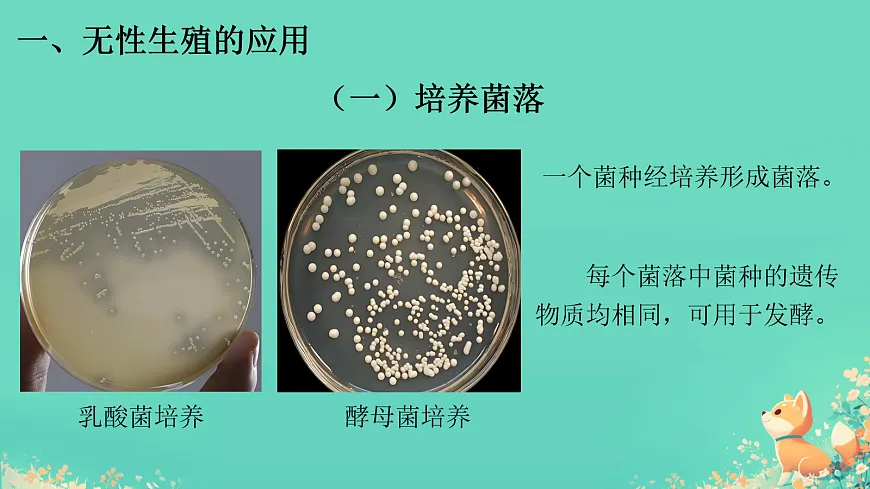
17992891第8页

生物人教版(2024)第一节 无性生殖课文配套课件ppt
展开 这是一份生物人教版(2024)第一节 无性生殖课文配套课件ppt,共48页。PPT课件主要包含了本课总结等内容,欢迎下载使用。
想一想,议一议: 竹子开花较为少见,大多数竹子开花后会死亡。在大熊猫的栖息地,大片竹子开花会影响大熊猫的生存。很少开花的竹子如何长成郁郁葱葱的竹林呢?
下列植物分别通过什么器官来繁殖后代的呢 ?
红薯块根发芽 马铃薯块茎发芽 竹鞭上的芽→竹笋→新竹子
多肉 大蒜发芽 椒草叶长根
下列动物分别通过什么来繁殖后代的呢 ?
下列微生物(细菌、真菌)分别通过什么来繁殖后代 ?
分裂生殖:细菌和草履虫
出芽生殖:酵母菌和水螅
叶:多肉、椒草根: 红薯茎:马铃薯、竹子
2.它们的新个体来自哪里?这是什么生殖方式?
1.这些生物新个体的产生需要精子和卵细胞结合吗?
无性生殖 :不经过两性生殖细胞的结合,由母体直接产生新个体的生殖方式。
3.无性生殖有何特点,这对生物生存繁衍有何意义 ?
2.迅速繁殖大量后代,快速占领环境,利于物种的生存和发展。
1.遗传物质和母体相同,能保持母体的优良性状。
一个菌种经培养形成菌落。
每个菌落中菌种的遗传物质均相同,可用于发酵。
剪取带芽的一段枝条,把枝条下部插入湿润的土壤中,或水中,不久这些枝条就会生根发芽,长成新植株。
甘薯.葡萄.菊.月季等
①上方切口 :②下方切口 :③去掉大部分 :
可减少水分的散失和切口受感染的机会。
可增加吸收水分的面积。
可降低叶片的蒸腾作用。
就是把一个植物体的芽或枝,接在另一个植物体上,使结合在一起的两部分长成一个完整的植物体。
嫁接成活后接穗所结的果实与 相同
使接穗与砧木的形成层紧密结合
①什么是植物组织培养? 在无菌条件下,将植物的茎尖、叶片、茎段等,在人工配置的培养基上培养,并诱导它们发育成“试管苗”,进而得到完整植株。
将枝条从植株上弯下来,并将枝条的一部分埋于土中,待其生根后再与母体断开。
不经过两性生殖细胞的结合,由母体直接发育成新个体。
可保持亲本的优良性状,繁殖速度快。
一.无性生殖的特点和意义1.定义:2.优势:
1.扦插2.嫁接:接穗和砧木的形成层紧密结合。3.组织培养
1.判断(1)将马铃薯的块茎切成小块种植时,不一定每块都要芽眼( )(2)在种植菊和芦荟时,一株植株常会变成一丛,这时可以把它们分成很多株,这种繁殖方式属于无性生殖( )
2.无性生殖是一类不经过_________________,由______直接产生_______的生殖方式。营养生殖是指____________依靠营养器官(____、____、____)进行的_______生殖。常见的营养生殖的方式有_______、_______;举例生产生生活中无性生殖的实例(至少两例):
根 茎 叶
①马铃薯块茎发芽, ②椒草的叶发芽,③月季花枝条、柳树枝条扦插 , ④树木、仙人掌的嫁接
3.有些植物既能进行有性生殖,又能进行无性生殖,这种特性有什么适应意义?
既可以在环境适宜的条件下通过无性繁殖迅速的扩大种群规模,占据时空资源。又可以在环境条件恶劣的情况下以有性生殖的果实或者种子度过不良的环境!让种族延续。
4、看操作步骤示意图,分析回答:(1)图中操作步骤是在生产实践中常见的 方式,属于 生殖。(2)①称为 ,②称为 。嫁接的关键点①与②结合时应当使①与②的 紧密结合,以确保①的成活。(3)枝接是图____,芽接是图____。(4)新形成的植株将表现出〔 〕 的性状。营养生殖的优点有加快植物的__________,保持亲本________。(5)小明家有毛桃树,丽丽家有水蜜桃树,小明从丽丽家剪取一枝水蜜桃枝条,嫁接在自己家毛桃树的一个树枝上,①小明家的桃树上会结_____种桃子。②接穗是_________枝条,会结_____桃;砧木是____桃枝条,会结_____桃。 (6) (列举两例)等很多果树都是利用这种方式来繁育优良品种的。
5、在酵母菌培养液中,许多酵母菌细胞上还连接着一个或多个小细胞,这是酵母菌正在进行( )A、有性生殖 B、无性生殖 C、营养生殖 D、嫁接6、一株苹果树上能结出“国光”、“红富士”、 “秦冠”等不同品种的苹果果实,采用的处理技术是( )A、扦插 B、压条 C、嫁接 D、播种7、下列生物的生殖现象属于出芽生殖的是( )A、利用秋海棠的叶进行生殖 B、利用小麦的种子进行生殖C、利用马铃薯上的芽进行生殖 D、酵母菌适宜条件下生殖8、下列哪项不属于无性生殖的优点 ( )A、繁殖速度快 B、保持亲本优良性状 C、提高后代的变异性和生活力 D、材料易得
相关课件
这是一份生物人教版(2024)第一节 无性生殖课文配套课件ppt,共15页。PPT课件主要包含了本课总结等内容,欢迎下载使用。
这是一份初中生物人教版(2024)八年级下册(2024)第一节 无性生殖教案配套课件ppt,共22页。PPT课件主要包含了学习目标,蒜的块茎,姜的块茎,莲的地下茎莲藕,葡萄的藤,无性生殖的意义,无性生殖的应用,课堂小结,练习与应用等内容,欢迎下载使用。
这是一份初中生物人教版(2024)八年级下册(2024)第一节 无性生殖集体备课课件ppt,共22页。PPT课件主要包含了想一想,竹子开花,竹笋生长,椒草的叶片长成新植株,植物利用营养器官生殖,水螅的出芽,酵母菌的出芽,草履虫的分裂,细菌的分裂,无性生殖的特点等内容,欢迎下载使用。
相关课件 更多
- 1.电子资料成功下载后不支持退换,如发现资料有内容错误问题请联系客服,如若属实,我们会补偿您的损失
- 2.压缩包下载后请先用软件解压,再使用对应软件打开;软件版本较低时请及时更新
- 3.资料下载成功后可在60天以内免费重复下载
免费领取教师福利 





.png)





